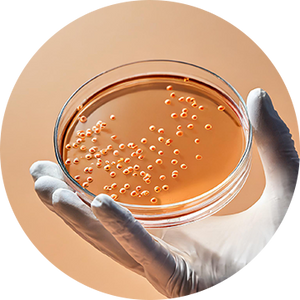

STAY DRY ABSORBENT PANTY
Modal | Mid Rise | Maple Sugar
₹899 (Incl. of all taxes)

-
Free Shipping Pan India
-
COD Available
- Discreet Delivery
Style & Fit
Wash & Care
Stay Dry. Feel Fresh.
Anywhere, Anytime
Meet your shield against icky wetness, after-toilet dampness, spotting, discharge, and crotch-swamp.
Whether you’re stuck without toilet paper, commuting for long hours or bracing for an unexpected period - life’s unpredictable, but your personal hygiene doesn’t have to be.
Use For:
-

Light
Spotting -

Daily
Discharge -

Irregular
Flow
Don't take our word for it.
Wash & Care Guide
Wash before first use. Certified to ensure safety, hygiene and no microbial contamination.
Kind To Your Body. Kind To The Planet.
It’s about bloody time you got a menstrual solution that's friendlier to your health, skin and environment.
FAQs
Stay Dry is the ideal panty for discharge, with instant absorption, a moisture-wicking top layer, liquid-locking core, and leak-blocking outer—all built-in without any bulk.
Stay Dry Absorbent Panty is just what you need! It’s the ideal underwear for discharge, light spotting after period, and even post-toilet dampness. Whether you’re dealing with unpredictable cycles or everyday leaks, it’s a safe, reusable, and toxin-free alternative to disposable panty liners—keeping you dry, comfortable, and eco-conscious without the bulk or waste.
Yes, absolutely. Stay Dry is a reusable alternative to panty liners—no plastic, bulk, or waste. It looks like regular underwear but absorbs light discharge, spotting after your period, and unpredictable flow with ease.
The last days of your cycle can be unpredictable—Stay Dry is perfect for light spotting after your period, brown discharge, or residual wetness, without the need for a pad or panty liner.
Daily use of disposable panty liners may cause heat, rashes, and irritation. Stay Dry Absorbent Panty offers a breathable, reusable alternative that’s gentle on your skin and a safer, eco-friendly choice for everyday freshness.
Skip the discomfort of liners and constant changes—Stay Dry Absorbent Panty is the perfect underwear for discharge. It keeps you feeling fresh and dry for hours, whether you're commuting, working, or on the move. A discreet, reusable upgrade from disposable panty liners, it’s designed for comfort, breathability, and everyday ease.
Absorbent Underwear like Stay Dry is made to eliminate wetness and keep you dry all day. Though not sweat-tested, many find it helpful in warm weather or on active days.
You can instead opt for Stay Dry Absorbent Panty. It is ideal for brown discharge after your period, especially on days you don’t want to wear a pad in your panties. Its hidden absorbent layer keeps you dry and protected, making it the perfect discharge underwear.
Panty liners can trap heat, cause irritation, and create non-biodegradable waste. Mahina's Stay Dry Absorbent Underwear is a breathable, reusable alternative—gentle on you and the planet.
Yes! Our period panty is made from soft, natural fabrics and tested to be free from harmful chemicals and PFAS free, giving you body-safe protection—no toxins, no irritation, no rashes!
Yes! Mahina is lab tested and certified on 20+ levels, including:
✔ Leakage Test (efficacy)
✔ Appearance Test (longevity)
✔ Peel Bond Strength Test (durability)
✔ Toxicology Test (Lab Tested, Free of Hazardous Chemicals, PFAS Free, Toxic Free)
✔ Microbiology Test (No Bioburden)
✔ 100 Wash Test (Durability)
[Click here] to learn more.
Yes! Our panties are batch-tested daily to last 100 washes—no pilling, shape loss, or leaks. We also run peel bond strength tests to ensure our bonding stays strong and secure.
Mahina is bioburden-tested in NABL-accredited labs to ensure it's free from harmful microbes and meets the highest hygiene standards.
Your laundry is safe! Just give our washable absorbent panties a quick rinse, then toss them in with your regular wash. They’re safe, stain-free, and easy to wash and use again and again!
Definitely! Our overnight absorbent panties keep you leak free, rash free, and stain free for up to 12 hours—so no waking up to change pads or tampons. Sleep easy in our ultra-soft absorbent panties.
Yes! Our Period Panties are designed for comfort and movement—no rashes, no leaks. Perfect for yoga, gym, athletics, travel, or light exercise. Not suitable for swimming.
Yes! Mahina comes in 7 sizes ranging from XS to 3XL in both Mid and High Rises. All our period & absorbent panties feature 4-way stretch and fit all body types like a gentle hug.
Check our size guide for accurate measurements, or book a tele-consultation with our experts to find your perfect fit.
Log in, head to ‘My Orders,’ and click your Order ID to track it. You’ll also get updates via email, SMS, and WhatsApp.
Go to ‘My Orders’ on our app or site, select your order, and click ‘Cancel’ (before it ships). Need help? Email care@mahina.co.
We can definitely help you! Reach us at care@mahina.co or call +91 92059 95271 (Mon–Sat, 9 AM–7 PM, excluding holidays).
Once your return reaches our warehouse and clears the quality check, your refund will be processed within 72 hours.
We offer free standard shipping for all domestic orders.
Delivery takes 3-7 business days, depending on your location.
If your order hasn’t been shipped, contact Customer Support for assistance. Once shipped, making changes are difficult but we’ll do the best we can.
Yes! We follow strict hygiene and safety measures to ensure your Mahina underwear is hygienically packed and remains uncompromised.